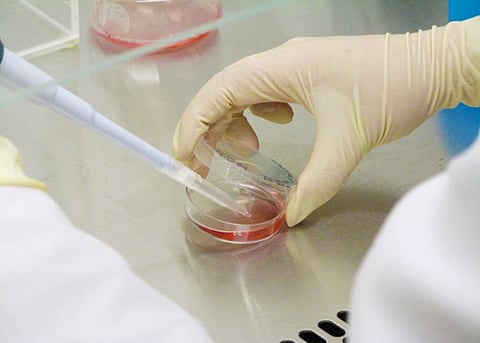

حصلت الأكاديمية بجامعة الطائف الدكتورة سارة بن محمد البقمي، على براءة اختراع في العلاجات الجينية المناعية، عن اختراعها "تحوير بروتين ما قبل الارتباط PLAD في مستقبل عامل نخر الورم TNFR1".
وحمل الاختراع رقم ٥١٧٦ بتاريخ 1438/3/16هـ من مكتب البراءات السعودي بمدينة الملك عبدالعزيز للعلوم والتقنية.
وأوضحت "البقمي" أن الاختراع عبارة عن طريقة علمية جديدة يتم فيها استخدام تطبيقات التقنية الحيوية الجزيئية المتقدمة بهدف إنتاج جيل جديد من العلاجات الجينية المناعية المتخصصة، حيث تم تطوير أحد القواعد النيتروجينية من جين TNFR1-PLAD بهدف زيادة ارتباط البروتين المحور الناتج مع نوع معين من بروتينات مستقبلات نخر الورم المتواجدة على أسطح الخلايا، وبالتالي إيقاف النشاط المفرط لهذه المستقبلات والتي غالباً ما يؤدي فرط نشاطها إلى استماتة Apoptosis أو التهاب Inflammation للخلايا.
يُذكر أن الدكتورة سارة البقمي تعمل أستاذًا مساعدًا في قسم التقنية الحيوية، وعضو هيئة التدريس في كلية العلوم جامعة الطائف.